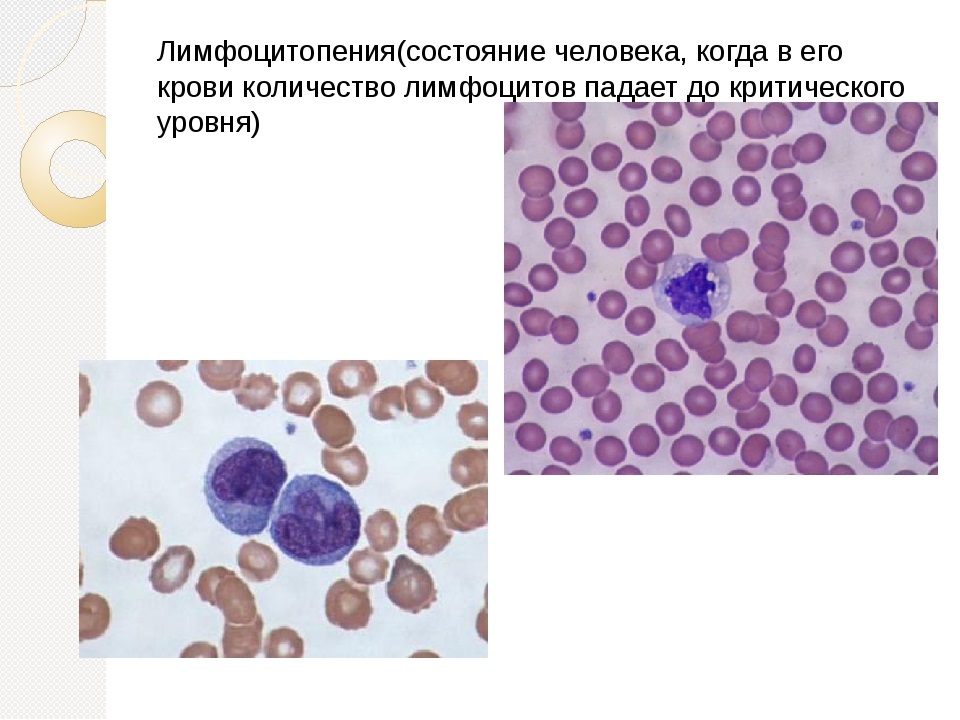

Пониженные лимфоциты в крови ребенка могут сигнализировать о проблемах со здоровьем. Лимфоциты важны для иммунной системы, и их снижение может указывать на воспалительные процессы, скрытые инфекции или нарушения в кишечнике. В статье рассмотрим причины понижения уровня лимфоцитов, а также методы диагностики и лечения, что поможет родителям лучше понять состояние здоровья ребенка и вовремя обратиться за медицинской помощью.
Что такое лимфопения
Лимфоциты представляют собой клетки, которые вырабатываются иммунной системой человека. Они формируются в костном мозге и перемещаются по организму с помощью лимфатической жидкости. Эти клетки способны распознавать антигены, связанные с опасными заболеваниями, и подавлять их размножение. После уничтожения вируса иммунная система «запоминает» его, что позволяет предотвратить повторное заражение.
Лимфоциты Т и В одинаково эффективно защищают организм от инфекций. Врачи разработали нормы для детей, которые используются при диагностике заболеваний:
- младенцы до 1 года – от 4 до 10,5×10^9/л;
- дети младшего дошкольного возраста до 4 лет – от 2 до 7×10^9/л;
- дети в возрасте от 4 до 10 лет – от 1,5 до 6,5×10^9/л;
- подростки до 18 лет – от 1 до 4,7×10^9/л.
При интерпретации анализа терапевт учитывает возраст ребенка. Важно также знать о состоянии здоровья его близких, как в семье, так и в детском коллективе. В некоторых случаях отклонения могут быть вариантом нормы и зависеть от индивидуальных особенностей. Если уровень лимфоцитов в крови оказывается низким, ставится диагноз «лимфопения».
Лимфоцитопения – это патологическое состояние, которое может свидетельствовать о наличии скрытых инфекций в организме. Это также может указывать на нарушения в работе внутренних органов и ослабление иммунной защиты. Однако анализ не способен выявить источник проблемы, и для этого требуется дополнительная диагностика.
Важно!
Низкий уровень лимфоцитов часто наблюдается у новорожденных, так как их организм только начинает знакомиться с патогенной микрофлорой. По мере формирования иммунной системы такая патология обычно проходит самостоятельно.

Пониженные лимфоциты в крови у ребенка могут свидетельствовать о различных состояниях, и мнение врачей по этому вопросу разнообразно. Одной из основных причин является вирусная инфекция, которая может временно подавлять иммунный ответ. Врачи также отмечают, что недостаток лимфоцитов может быть связан с хроническими заболеваниями, такими как аллергии или аутоиммунные расстройства. Кроме того, недостаточное питание, особенно дефицит витаминов и минералов, может негативно сказаться на уровне лимфоцитов. Важно учитывать, что пониженные лимфоциты не всегда указывают на серьезные проблемы, но требуют внимательного наблюдения и, при необходимости, дополнительных исследований для определения причины. Врачам рекомендуется проводить комплексную оценку состояния ребенка, чтобы установить точный диагноз и назначить соответствующее лечение.
Виды лимфоцитопении
Врачи классифицируют снижение уровня лимфоцитов в зависимости от его причин, что позволяет более точно подобрать терапию:
- Абсолютная. Этот тип всегда связан с нарушением работы костного мозга, который перестает производить защитные клетки. Она может возникать на фоне онкологических заболеваний, болезней почек или ВИЧ. Часто такая проблема наблюдается после химиотерапии или при длительном применении высоких доз гормонов.
- Относительная. В данном случае в лейкоцитарной формуле фиксируется значительный рост нейтрофилов на фоне снижения лимфоцитов. Такой дисбаланс может быть вызван острыми или хроническими инфекциями, а также воздействием вирусов и бактерий.
- Врожденная. Этот тип патологии формируется еще в эмбриональном периоде и может быть вызван опасными вирусами, которые передаются от матери к плоду.
- Приобретенная. Лимфопения этого типа возникает из-за нехватки витаминов и микроэлементов, а также может быть связана с неблагоприятными условиями жизни ребенка.
В зависимости от стадии заболевания выделяют острые и хронические формы. В редких случаях может развиваться ятрогенная лимфопения, которая возникает при длительном использовании мощных медикаментов.
https://youtube.com/watch?v=vzCrwWRtlmE
| Причина пониженных лимфоцитов (лимфопения) | Краткое описание | Возможные действия/дальнейшие шаги |
|---|---|---|
| Вирусные инфекции | Наиболее частая причина. Многие вирусы (грипп, ОРВИ, корь, краснуха, ВИЧ, Эпштейн-Барр) временно подавляют выработку лимфоцитов или разрушают их. | Обычно проходит самостоятельно после выздоровления. Наблюдение, симптоматическое лечение. При подозрении на серьезные инфекции – специфическая диагностика и лечение. |
| Бактериальные инфекции | Тяжелые бактериальные инфекции (сепсис, брюшной тиф) могут вызывать перераспределение лимфоцитов или их разрушение. | Лечение основной бактериальной инфекции антибиотиками. |
| Стресс и физическое перенапряжение | Сильный стресс (например, после операции, травмы, сильного эмоционального потрясения) может временно снижать количество лимфоцитов. | Устранение стрессового фактора, обеспечение покоя и восстановления. |
| Прием некоторых лекарств | Кортикостероиды, иммунодепрессанты, некоторые химиотерапевтические препараты могут подавлять выработку лимфоцитов. | Оценка необходимости приема препарата, коррекция дозы или замена по согласованию с врачом. |
| Аутоиммунные заболевания | Системная красная волчанка, ревматоидный артрит и другие аутоиммунные состояния могут приводить к разрушению лимфоцитов собственным организмом. | Диагностика и лечение основного аутоиммунного заболевания. |
| Врожденные иммунодефициты | Редкие генетические нарушения, при которых нарушается развитие или функция лимфоцитов (например, тяжелый комбинированный иммунодефицит). | Специализированная диагностика и лечение в условиях иммунологического центра. |
| Заболевания костного мозга | Апластическая анемия, лейкозы, миелодиспластические синдромы могут нарушать нормальное кроветворение, включая выработку лимфоцитов. | Гематологическое обследование, диагностика и лечение основного заболевания. |
| Недостаточность питания | Дефицит некоторых витаминов (например, фолиевой кислоты, B12) или белка может влиять на кроветворение. | Коррекция диеты, прием витаминных добавок по назначению врача. |
| Потеря лимфоцитов | Например, при обширных ожогах, энтеропатии с потерей белка, дренировании лимфатических протоков. | Лечение основного состояния, восполнение потерь. |
| Ионизирующее излучение | Воздействие радиации может повреждать клетки костного мозга, включая предшественники лимфоцитов. | Избегание источников радиации, симптоматическая терапия при лучевой болезни. |
Причины низкого уровня лимфоцитов у ребенка
Врачи не рассматривают лимфопению как самостоятельное заболевание. Клетки иммунной системы постоянно образуются в селезенке, тимусе, костном мозге и лимфатических узлах. При повреждении этих органов уровень выработки снижается, что можно выявить по анализу лейкоцитарной формулы.
Вторая причина снижения лимфоцитов в крови встречается реже. У ребенка может производиться достаточное количество клеток, однако они быстро разрушаются под воздействием различных факторов. К таким факторам относятся серьезные аутоиммунные заболевания и генетические аномалии.
Абсолютная лимфопения
Патология возникает из-за нарушений в функционировании костного мозга у детей. Она диагностируется при уровне лимфоцитов ниже 1,8×10^9/л. Это состояние может быть как врожденным, так и приобретенным в результате следующих заболеваний:
- онкологические новообразования;
- острая почечная недостаточность;
- терапия гормональными средствами на основе кортикостероидов;
- расстройства кроветворения;
- лейкемия;
- ВИЧ-инфекция.
При абсолютной форме заболевания уровень лимфоцитов у ребенка может снижаться до критически низких значений. На фоне этого могут развиваться вирусные инфекции с серьезными осложнениями, такими как бронхит, пневмония и миокардит. Данное состояние часто наблюдается после проведения лучевой и химиотерапии.
Относительная лимфопения
Количество лимфоцитов в организме может снижаться на 18–20% при увеличении других клеток в лейкоцитарной формуле. Чаще всего такой дисбаланс свидетельствует о наличии воспалительного процесса. Это отклонение может указывать на ряд заболеваний, таких как:
- грипп;
- корь;
- паротит;
- дифтерия;
- краснуха;
- полиомиелит.
В некоторых случаях снижение лимфоцитов может помочь на ранних стадиях выявить артрит после перенесенной ангины, красную волчанку и другие серьезные заболевания. У детей пониженное количество лимфоцитов в крови может наблюдаться при ОРВИ, коклюше, а также при нарушениях работы печени, закупорке желчных протоков и воспалении слизистой оболочки кишечника.
Важно!
Сниженные лимфоциты могут указывать на наличие заболевания и служат своеобразным индикатором скрытых проблем. Однако для точного определения причины необходимо провести комплексную диагностику и дополнительные анализы.
Ятрогенная лимфопения
У детей, рожденных от матерей, страдающих от ВИЧ или онкологических заболеваний, часто наблюдается резкое снижение уровня лимфоцитов. Это связано с тем, что у женщины отсутствует полноценная иммунная защита, а также с воспалительными процессами, возникающими во время беременности. В некоторых случаях для сохранения эмбриона необходимо использовать препараты, которые могут оказывать влияние на органы новорожденного.
Приобретенная форма ятрогенной лимфоцитопении возникает в результате приема определенных медикаментов. Это побочный эффект, при котором лимфоциты подвергаются быстрому разрушению. Данное состояние может возникнуть при длительном использовании антибиотиков, гормональных препаратов и иммуноглобулинов. Уровень клеток восстанавливается после прекращения приема «агрессивных» лекарственных средств.
Симптомы и признаки
Определить снижение уровня лимфоцитов можно только с помощью лабораторных исследований, так как не существует специфических симптомов лимфоцитопении. Чаще всего родители узнают о наличии проблемы после диагностики основного заболевания или при проведении общего анализа крови. Есть несколько характерных признаков, при которых стоит обратиться к врачу:
- продолжительное повышение температуры;
- частые простудные заболевания с осложнениями;
- увеличение лимфоузлов;
- общая слабость;
- бледность кожи;
- высыпания на коже.
При снижении уровня лимфоцитов в крови у ребенка могут возникнуть болезненные эрозии в ротовой полости, десны могут опухать и вызывать зуд. При пальпации может быть обнаружено увеличение селезенки. Дети могут проявлять отказ от еды и игрушек, а также испытывать трудности с усвоением учебного материала. Часто обостряются хронические заболевания сердечно-сосудистой системы, кишечника и печени.

Чем опасна лимфопения
Если уровень лимфоцитов снизился после перенесенной простуды, здоровый организм способен самостоятельно восстановить нормальный баланс. Однако при длительном нарушении этого показателя требуется медицинское вмешательство и соблюдение специальной диеты. Врачи настоятельно рекомендуют не игнорировать дополнительное обследование ребенка, так как на ранних стадиях могут проявляться такие заболевания, как лейкемия или туберкулез.
При пониженных лимфоцитах дети труднее переносят респираторные инфекции. Они чаще подвержены ОРВИ, гриппу и ротавирусным инфекциям. У таких детей наблюдаются проблемы с аппетитом и успеваемостью, а также может начаться отставание в росте и весе.
Обратите внимание!
К факторам риска, способствующим снижению выработки лимфоцитов, относятся авитаминоз, неправильное питание и проживание в экологически неблагоприятных районах.
Особенности лечения
При выявлении лимфопении специалисты проводят комплексное обследование для определения причины данного состояния. Важно выполнить общий анализ крови и мочи, а также получить консультации отоларинголога, терапевта и гастроэнтеролога. Кроме того, могут быть назначены иммунограмма, биохимический анализ, а также ультразвуковое исследование печени, щитовидной железы и почек.
Для лечения воспалительных процессов у детей назначаются курсы иммуноглобулинов. Эти препараты, основанные на плазменных соединениях, содержат антитела. После их введения происходит активизация выработки лимфоцитов, что способствует восстановлению иммунной системы. В результате организм способен самостоятельно бороться с инфекцией без возникновения осложнений.
При воспалительных процессах, вызванных аутоиммунными заболеваниями, необходимо использовать:
- глюкокортикостероиды;
- антибиотики на основе аминохинолина;
- иммуносупрессанты.
После стабилизации состояния детям подбираются препараты, которые помогают контролировать заболевание и замедляют его прогрессирование. В случае повышения температуры и лихорадки важно применять жаропонижающие средства, такие как Ибупрофен, Нурофен или Парацетамол. Витаминные комплексы помогут поддержать силы организма и улучшить аппетит.
Лейкоз крови, неходжкинские лимфомы и лимфогранулематоз требуют длительного лечения. На начальном этапе применяется химиотерапия, что позволяет подавить рост злокачественных клеток и уменьшить обострение. Если химиотерапия оказывается неэффективной, может быть рекомендована пересадка костного мозга от донора.
Диета при пониженных лимфоцитах
При легкой степени снижения клеток в крови врачами рекомендуется внести изменения в рацион питания детей. Основная проблема может заключаться в недостатке белков, которые необходимы для формирования лимфоцитов. Чтобы рассчитать суточную норму белка, нужно умножить вес ребенка в килограммах на коэффициент 0,8.
Для приготовления блюд стоит выбирать нежирные виды мяса и рыбы, такие как телятина, курица, индейка и хек. Рекомендуется запекать их в собственном соку с овощами и растительным маслом.
Среди дополнительных советов от диетологов:
- Включать в рацион продукты, богатые бета-каротином: морковь, шпинат, курагу и тыкву.
- Заправлять салаты оливковым маслом и избегать покупных соусов.
- Предлагать свежевыжатые соки, домашние морсы и некрепкий чай.
- На время исключить сладости и выпечку, так как избыток углеводов может снижать выработку лимфоцитов.
- Готовить перекусы для школьников с использованием зернового хлеба, который содержит селен, цинк и витамины группы В.
Рацион должен быть сбалансирован по содержанию белков, жиров и углеводов. В первые дни после выявления лимфопении полезно увеличивать потребление цитрусовых и свежих яблок, так как они богаты витамином С, который поддерживает иммунную систему. Для выведения токсинов и улучшения лимфодренажа ребенку следует пить чистую негазированную воду. У большинства маленьких пациентов уровень клеток восстанавливается в течение 4–6 недель.
Профилактика
Снижение уровня лимфоцитов в крови у детей может привести к различным осложнениям. Поэтому родителям важно помнить о мерах профилактики:
- контролировать сбалансированное питание в школе, дома и в детском саду;
- по рекомендации врача использовать витаминные комплексы;
- чаще проводить время на свежем воздухе с ребенком;
- внедрять закаливание в повседневную практику.
Рекомендуется записать ребенка в спортивную секцию, на танцы или в бассейн. При этом важно избегать переутомления и создать комфортные условия для отдыха. Врачи советуют своевременно лечить ОРВИ и не допускать затяжного кашля или насморка. Не стоит злоупотреблять иммуностимуляторами, так как синтетические препараты могут оказать противоположный эффект и ослабить защитные функции организма.
Лимфоциты – это клетки крови, которые играют ключевую роль в формировании иммунной защиты. При их снижении ребенок становится уязвимым к опасным инфекциям и вирусам. Для выявления данной проблемы необходимо регулярно посещать педиатра и сдавать анализы крови. Профилактика включает в себя правильное питание, активные занятия спортом и полноценный сон.
Диагностика лимфопении
Диагностика лимфопении у ребенка начинается с общего анализа крови, который позволяет определить уровень лимфоцитов. Лимфоциты — это один из видов белых кровяных клеток, играющих ключевую роль в иммунной системе. Нормальные значения лимфоцитов могут варьироваться в зависимости от возраста ребенка, поэтому важно учитывать возрастные нормы при интерпретации результатов анализа.
Если уровень лимфоцитов ниже нормального диапазона, это состояние называется лимфопенией. Для диагностики лимфопении необходимо не только зафиксировать низкий уровень лимфоцитов, но и выяснить причины этого состояния. Врач может назначить дополнительные исследования, такие как:
- Повторный анализ крови: Для исключения ошибок в первом анализе и подтверждения диагноза.
- Биохимический анализ крови: Для оценки функции печени и почек, а также уровня электролитов и белков.
- Иммунологические тесты: Для оценки состояния иммунной системы и выявления возможных нарушений.
- Микробиологические исследования: Для выявления инфекций, которые могут быть причиной лимфопении.
- МРТ или КТ: В некоторых случаях может потребоваться визуализация органов для исключения опухолевых процессов или других патологий.
Важно также учитывать клинические проявления, которые могут сопутствовать лимфопении. Это могут быть частые инфекции, усталость, слабость, а также другие симптомы, указывающие на возможные заболевания. Врач должен провести тщательный опрос и физикальное обследование, чтобы выявить сопутствующие симптомы и определить, требуется ли дальнейшее обследование.
Лимфопения может быть следствием различных факторов, включая вирусные инфекции, аутоиммунные заболевания, генетические нарушения, а также побочные эффекты от некоторых лекарств. Поэтому важно не только установить факт наличия лимфопении, но и выявить ее причину, чтобы назначить адекватное лечение и предотвратить возможные осложнения.
В заключение, диагностика лимфопении у ребенка требует комплексного подхода, включающего анализы, клиническое обследование и оценку состояния иммунной системы. Это позволяет не только подтвердить диагноз, но и выявить основное заболевание, требующее лечения.
Роль иммунной системы в организме ребенка
Иммунная система играет ключевую роль в защите организма ребенка от инфекций и заболеваний. Она состоит из различных клеток и молекул, которые взаимодействуют друг с другом для обеспечения иммунного ответа. Лимфоциты, в частности, являются важной частью этой системы, так как они отвечают за распознавание и уничтожение патогенов, таких как вирусы и бактерии.
Существует несколько типов лимфоцитов, включая Т-клетки, В-клетки и естественные киллеры. Т-клетки помогают регулировать иммунный ответ и уничтожают инфицированные клетки, в то время как В-клетки производят антитела, которые связываются с патогенами и нейтрализуют их. Естественные киллеры играют роль в первой линии защиты, распознавая и уничтожая клетки, которые могут представлять угрозу для организма.
Уровень лимфоцитов в крови может варьироваться в зависимости от возраста ребенка, состояния его здоровья и наличия инфекций. Нормальные значения лимфоцитов у детей могут колебаться, но в целом они составляют от 20% до 50% от общего числа лейкоцитов. Пониженные уровни лимфоцитов, известные как лимфопения, могут указывать на различные проблемы со здоровьем и требуют внимательного анализа.
Лимфопения может быть вызвана несколькими факторами, включая вирусные инфекции, такие как грипп или ВИЧ, а также бактериальные инфекции, аутоиммунные заболевания, недостаток питательных веществ, такие как витамин B12 или фолиевая кислота, и некоторые генетические расстройства. Важно отметить, что пониженные лимфоциты могут также возникать в результате воздействия определенных лекарств, таких как кортикостероиды, которые подавляют иммунный ответ.
При обнаружении пониженных лимфоцитов у ребенка необходимо провести дополнительные исследования для выяснения причины этого состояния. Врач может назначить анализы крови, чтобы оценить другие компоненты иммунной системы, а также провести обследование на наличие инфекций или других заболеваний. В зависимости от результатов, может потребоваться лечение, направленное на восстановление нормального уровня лимфоцитов и укрепление иммунной системы.
Таким образом, понимание роли лимфоцитов и факторов, влияющих на их уровень, является важным аспектом в поддержании здоровья ребенка. Родители должны быть внимательны к изменениям в состоянии здоровья своих детей и при необходимости обращаться за медицинской помощью для своевременной диагностики и лечения.
Психологические аспекты и поддержка семьи
Пониженные лимфоциты в крови у ребенка могут вызывать не только медицинские, но и психологические последствия для всей семьи. Когда родители узнают о том, что у их ребенка наблюдается лимфопения, это может стать источником стресса и беспокойства. Важно понимать, что эмоциональное состояние родителей и других членов семьи может существенно влиять на общее самочувствие ребенка.
Первоначально, родители могут испытывать страх и неуверенность. Они могут задаваться вопросами о причинах снижения уровня лимфоцитов, о том, как это повлияет на здоровье ребенка и какие меры необходимо предпринять. Эти переживания могут привести к повышенной тревожности, что в свою очередь может отразиться на эмоциональном состоянии ребенка. Дети очень чувствительны к настроению своих родителей, и их беспокойство может усугубить ситуацию.
Поддержка семьи играет ключевую роль в процессе лечения и восстановления. Важно создать атмосферу, в которой ребенок будет чувствовать себя в безопасности и защищенности. Родители должны стараться оставаться спокойными и уверенными, демонстрируя ребенку, что они готовы справиться с любыми трудностями. Это может включать в себя открытое обсуждение ситуации, где родители могут объяснить ребенку, что происходит, на доступном для него языке, и что они делают все возможное для его здоровья.
Кроме того, важно вовлекать других членов семьи в процесс поддержки. Бабушки, дедушки и братья или сестры могут стать важными источниками эмоциональной поддержки. Совместные занятия, такие как игры, чтение книг или прогулки на свежем воздухе, могут помочь укрепить семейные связи и отвлечь ребенка от негативных мыслей.
Не менее важным аспектом является обращение за профессиональной помощью. Психологи и психотерапевты могут предложить стратегии для управления стрессом и тревожностью, как для родителей, так и для ребенка. Группы поддержки для родителей детей с хроническими заболеваниями также могут стать полезным ресурсом, где можно обменяться опытом и получить советы от людей, которые сталкиваются с аналогичными проблемами.
В заключение, важно помнить, что пониженные лимфоциты в крови у ребенка — это не только медицинская проблема, но и ситуация, требующая внимания к психологическим аспектам. Поддержка семьи, открытое общение и профессиональная помощь могут значительно улучшить эмоциональное состояние как ребенка, так и его родителей, способствуя более успешному преодолению трудностей.